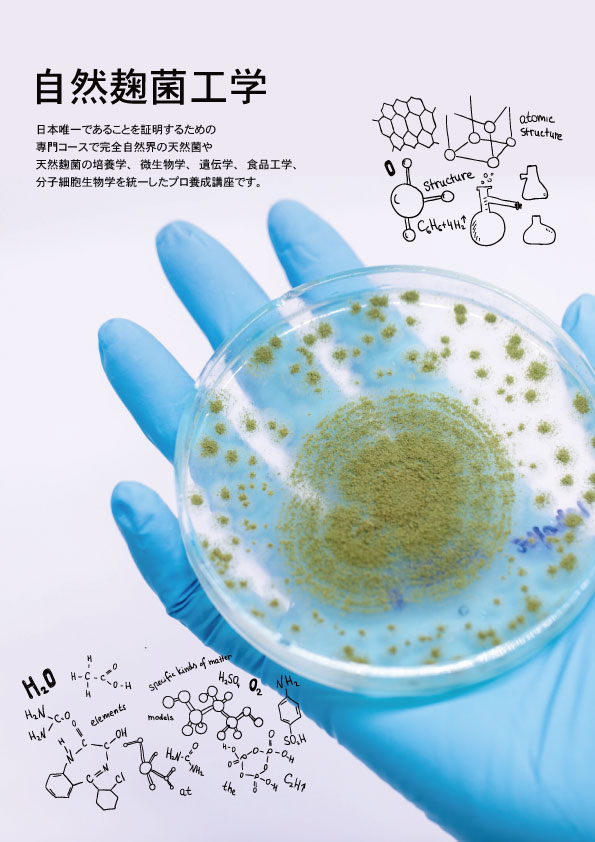
spe-kin001-01-sss

About Us

”食が間違うとどんな薬も効かない”、”正しい食を取るとどんな薬もいらない”、
これは大昔から先人たちが残してくれる名言です。本当の食をとってますかの質問に対し、
残念ながら本当の方はとっていますと答えたのです。
本物の食と発酵の技を、次世代の子供たちへ
本物の食と発酵の技を、次世代の子供たちへ
本物の調味料や食は、必ず自然の摂理と深く結びついています。
世代を超えて受け継がれる「発酵」の技。それはまるで童謡のように、親から子へと自然に口ずさまれ、継承されていくことが理想の姿ではないでしょうか。
私が研究している「自然発酵」の技は、すべては子供たちの未来と健康のためにあります。
我が子に将来の夢を尋ねたところ、「お父さんの天然味噌や天然酢を作って、病気の人たちを助ける仕事がしたい」と答えてくれました。私が伝えているのは、決して難しいことではありません。古来、先祖が遺してくれた知恵を現代の自然科学の視点で紐解き、分かりやすくお伝えしているだけなのです。
発酵の技を学ぶことは、一生の宝となります。そして何より、家族に笑顔をもたらします。
ここで一度、問いかけてみてください。「正しい食や調味料とは何か?」「今、お子様に何を届けているか?」と。
残念ながら、市販されている漬物の多くは「発酵食品」ではありません。現在、流通しているものの約98%が、保存性を優先した「非発酵」の加工食品であるという現実があります。裏ラベルを確認すれば、そこには想像を超える量の添加物が並んでいます。
2023年4月、世界的に権威のある科学誌『Nature』にて、市販の調味料に含まれる化学調味料や人工甘味料が、腸内細菌に深刻な悪影響を及ぼすという研究結果が発表されました。抗生物質を含む食品や添加物の摂取は、子供たちの腸内フローラを乱し、アトピー性皮膚炎や喘息、免疫疾患といった苦しみを引き起こす原因にもなり得ます。
子供たちは親から与えられる食がすべてです。
「集団無意識」による誤った情報に惑わされず、まずは親である私たちが賢くならなければなりません。一番の解決策は、親が自ら発酵食を作り、その背中を見せることです。時間をかけて丁寧に作る姿を通じて、子供たちは食の価値と尊さを学びます。
自ら手を動かし、経験から学ぶことで得られる気づきは、お金では買えない素晴らしい価値があります。その経験こそが、人生における最高のプレゼントになると私は信じています。

Kansaidou / Kim Hyo seouk
History

2015
日本で天然菌の培養に成功

2016
世界初、天然菌で日本の味噌に成功

2017
ザ韓菜堂ラボ設立

2017
非加熱甘酒の天然菌の培養に成功

2017
醤油や味噌、天然酢など商品化するシステムを導入

2018
天然菌で作る天然調味料の養成講座開始

2018
天然酢、天然味噌を商品化

2019
100種類の天然味噌商品化成功

2020
滋賀県の放送局に天然チーズ味噌紹介

2021
自然界の空気中の豆麹を直接培養技術と湯浅式の醤油養成講座開始

2021
自然界の天然麹菌直接培養方法の養成講座開始



